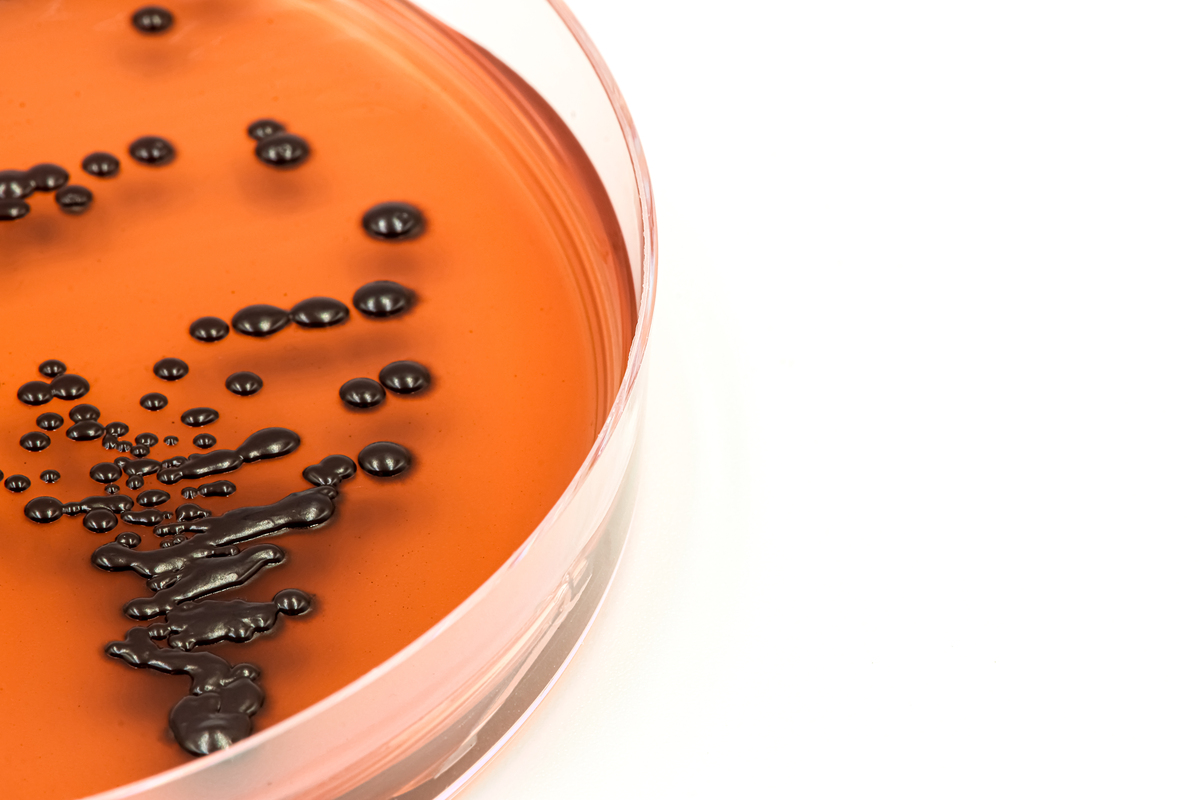
平板倾注法和涂布法计数：菌落差异及培养时间解析

平板倾注法和涂布法计数:菌落差异及培养时间解析
平板倾注法和涂布法是常见的微生物计数方法,两者的主要区别在于在平板上菌落的形成方式不同。
平板倾注法是将一定数量的细菌悬液倒入平板上,然后让其自然分布,最后在恰当条件下培养菌落。此方法可以在平板上形成均匀分布的菌落,但可能会产生菌落间的重叠。因此,平板倾注法计数的菌落数有时会低估实际数量。
涂布法是将一定数量的细菌悬液均匀涂抹在平板上,最后在恰当条件下培养菌落。此方法可以避免菌落之间的重叠,因此计数的菌落数更加准确。
在观察结果方面,涂布法的菌落通常较小,形态较规则;而平板倾注法的菌落则通常较大,形态不规则。这是由于平板倾注法的菌落在生长过程中会相互影响,导致形态不规则。
平板倾注法需要培养较长时间后观察结果是因为在菌落的形成过程中,每个菌落需要经历细胞分裂、营养代谢、分化等生长过程,这些过程需要时间。此外,有些菌种在平板上生长速度较慢,需要更长的时间才能形成可观察的菌落。因此,平板倾注法通常需要培养24-48小时或更长时间才能得到准确的计数结果。
原文地址: http://www.cveoy.top/t/topic/oav3 著作权归作者所有。请勿转载和采集!